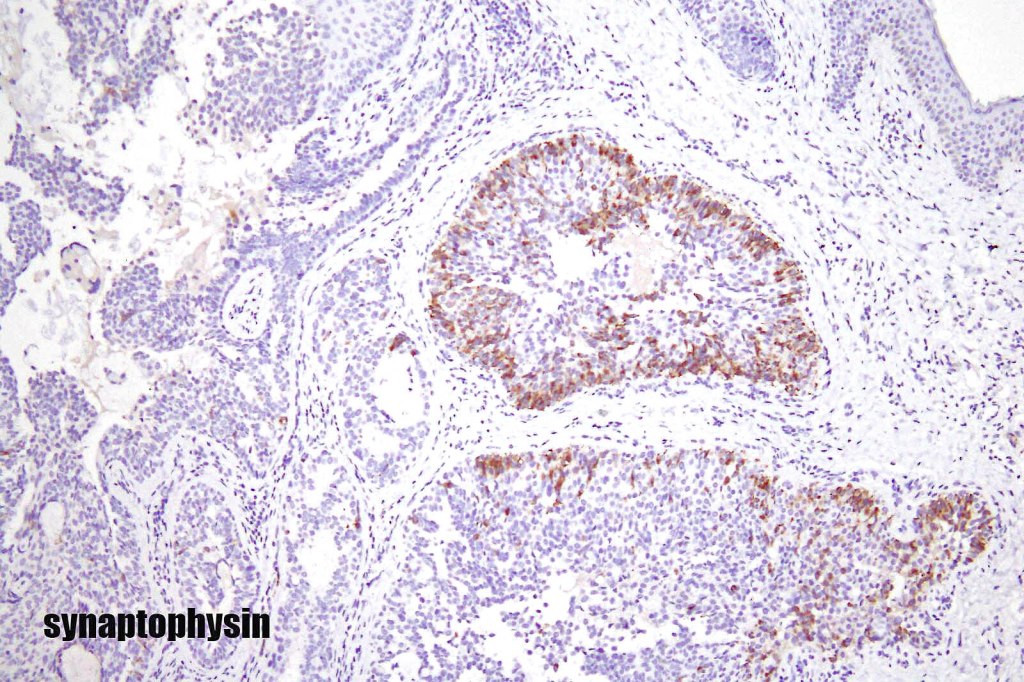
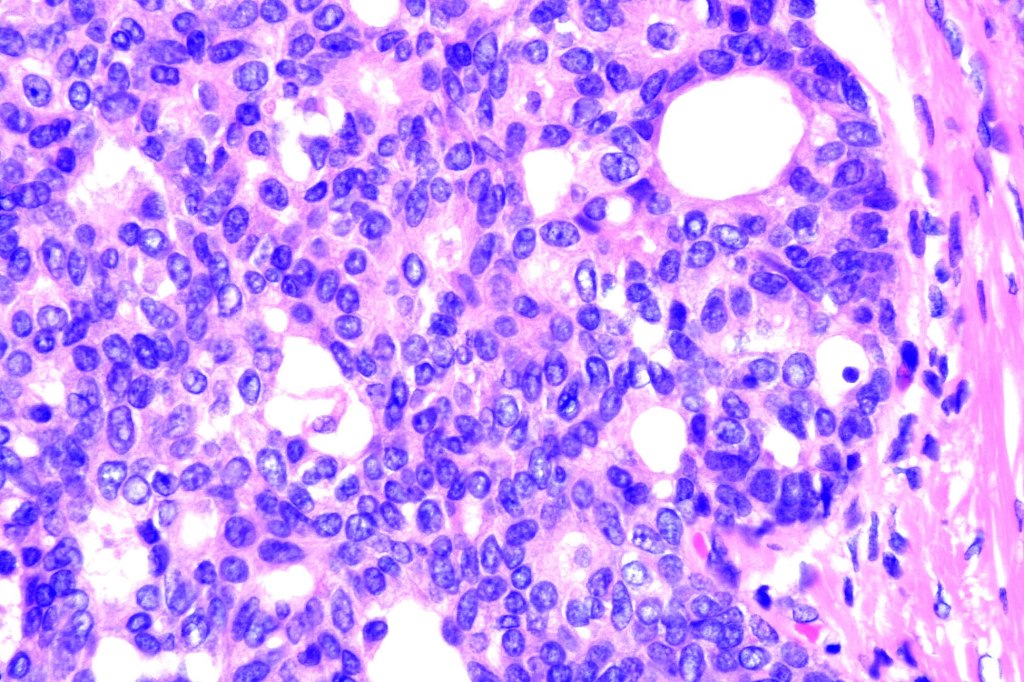
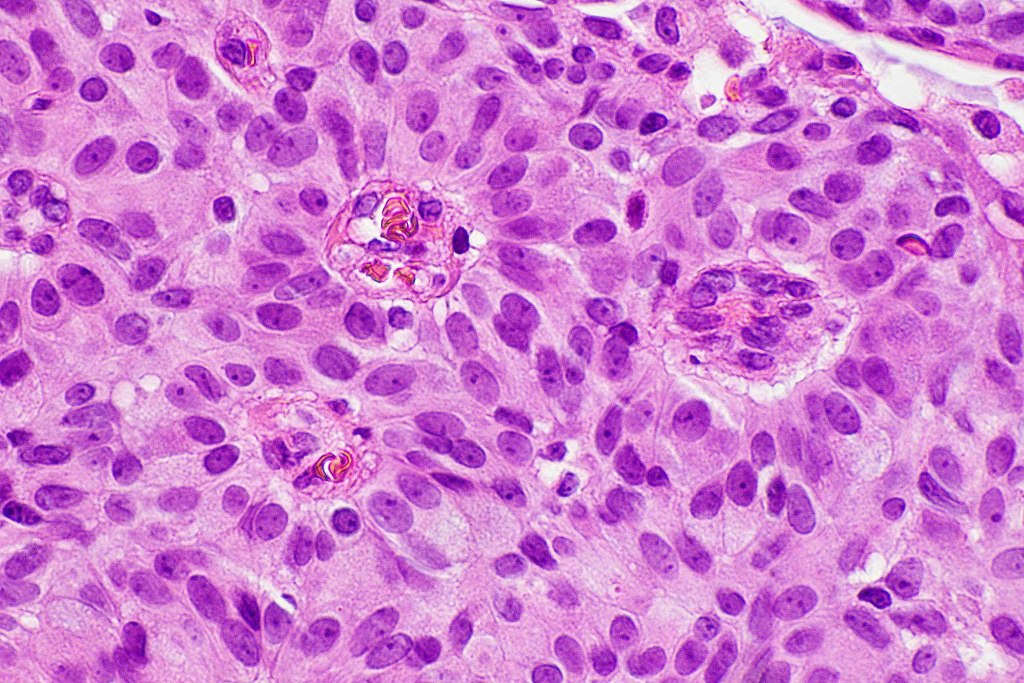

Endocrine mucin-producing sweat gland carcinoma & mucinous carcinoma are intrinsically linked. Indeed it is very likely that the former represents a pecurser to the latter. Very frequently an example shows histological features of both lesions (50% of cases).
Clinical features
•Mucinous carcinoma is rare & mostly affecting the middle-aged & elderly (mean 62 years (8-89))
•Presents as a solid or cystic, flesh colored or pink/blue nodule measuring 0.5- 2 cm diameter
•Predilection for eyelids but may affect the rest of the face, scalp, axillae etc
•Generally indolent but may recur in up to 26% of patients
•Nodal metastases are very rarely encountered
•EMPSGCa shows a predilection for the lower eyelid & cheek
•Elderly (48-84 years)
•Indolent but may recur
•No metastases
Histological features
•Mucinous carcinoma is characterized by epithelial islands dispersed in a rich mucinous stroma
•DPAS, colloidal iron & Alcian blue ph 2.5 +ve
•Eosinophilic cytoplasm & small vesicular nuclei
•Mitoses scanty to absent
•No significant pleomorphism
•+/- decapitation secretion
•Exceptionally, signet ring cells
•+/- in situ component
•CAM 5.2, AE1/AE3, CK7, estrogen receptor, progesterone receptor, mammaglobin, GATA3, GCDFP-15, EMA & CEA +ve
•CK20 –ve
•Myoepithelial cells p63, SMA & calponin +ve
•In a subset of tumors, neuroendocrine markers- synaptophysin, chromogranin & NSE +ve (neuroendocrine subtype)
. EMPSGCa shares this IHC profile
•EMPSGCa– multiple nodules of uniform epithelial cells with vesicular nuclei & small nucleoli
•In situ component sometimes evident
•+/- intracytoplasmic mucin
•Cyst formation sometimes evident
•Papillae & cribriform pattern sometimes evident
•+/- apocrine decapitation secretion
•No significant pleomorphism
•Few mitoses
•No abnormal mitoses
•+/- invasive mucinous carcinoma (50%)

Differential diagnosis
Mucinous carcinoma of the skin must be distinguished from a metastasis from a primary occuring at a myriad of other sites including the breast, gastrointestinal system, lung, ovary and elsewhere. Mucinous carcinoma of the breast is most unlikely to present with a metastasis in the absence of a known history of breast carcinoma. If there is any doubt, clinical investigations should settle the matter. Cutaneous mucinous carcinoma is CK7+ve/CK20-ve whereas GIT mucinous carcinoma is CK7-ve/CK20+ve
Leave a comment